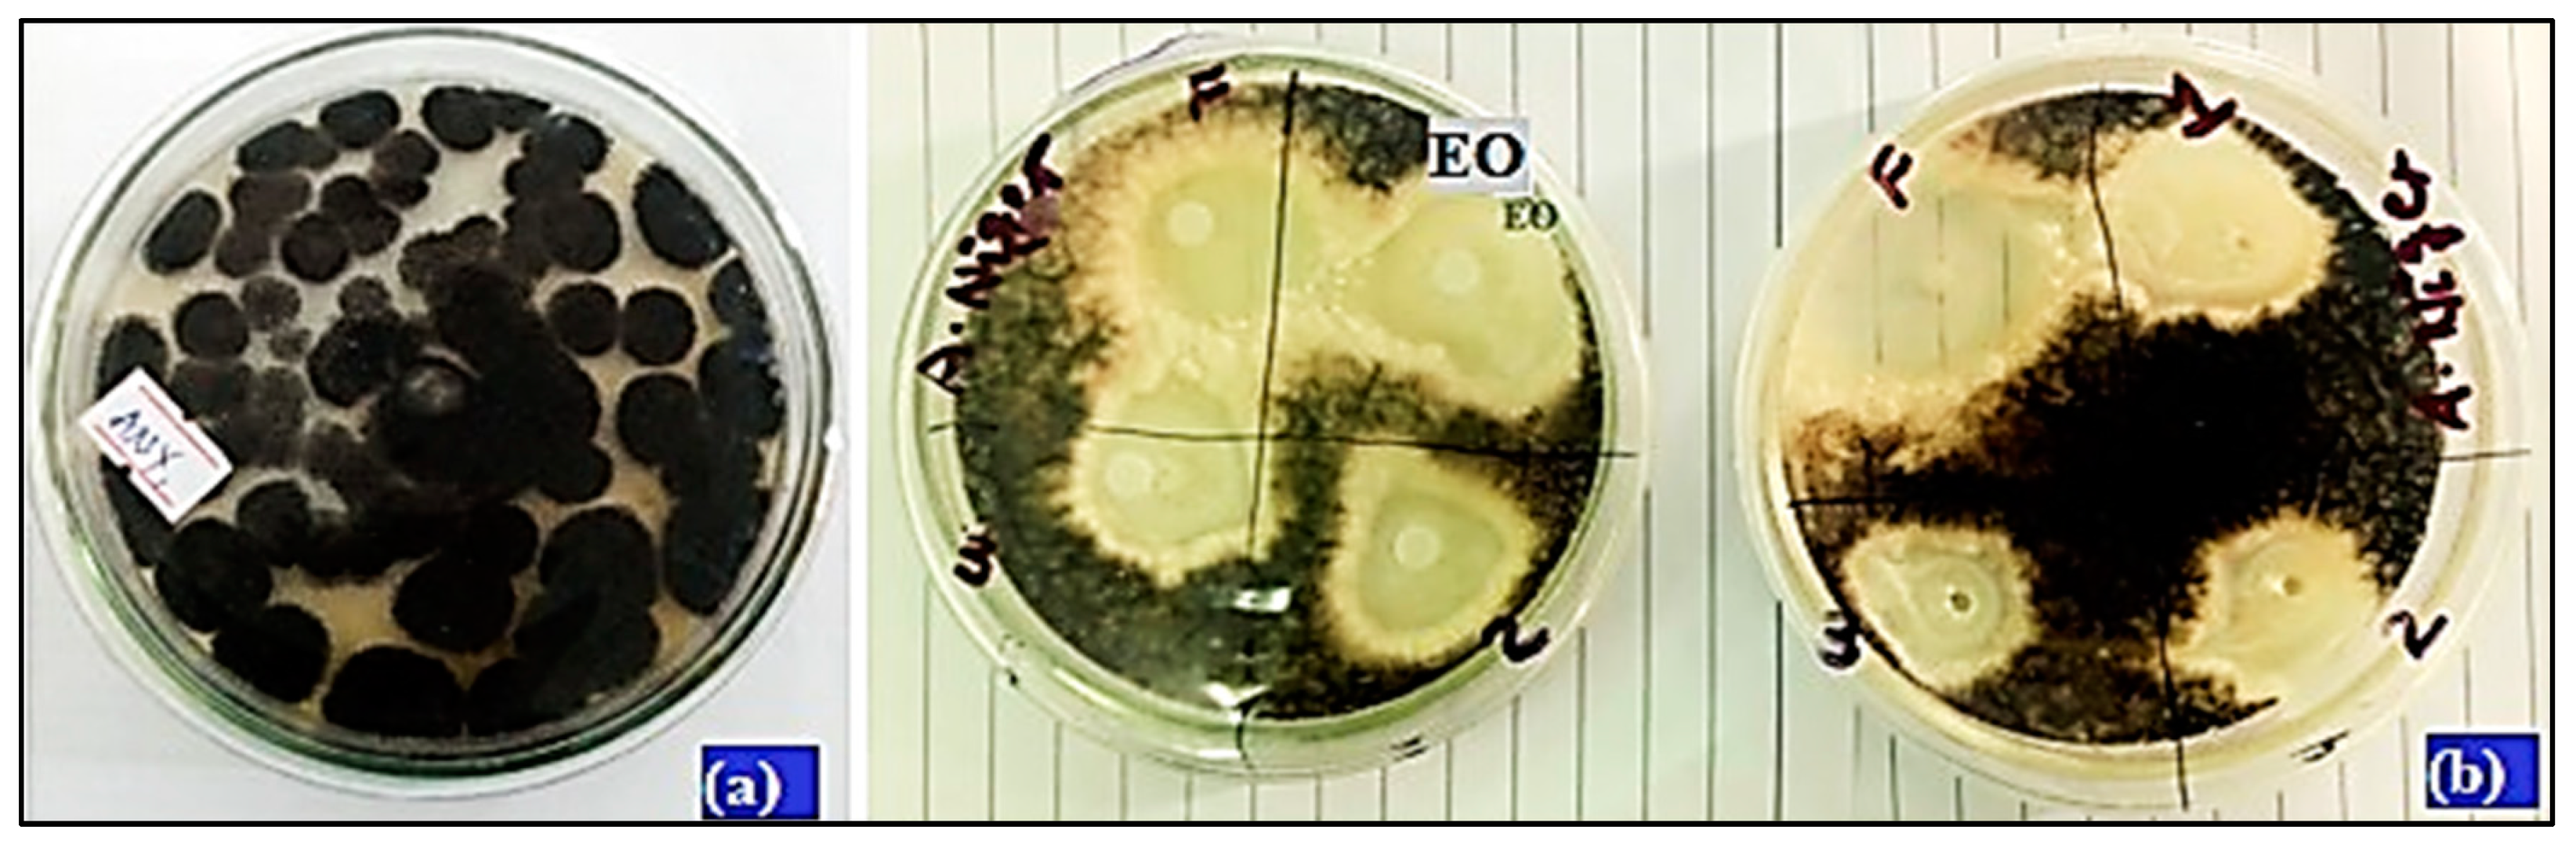
Sustainability 15 03189 g008
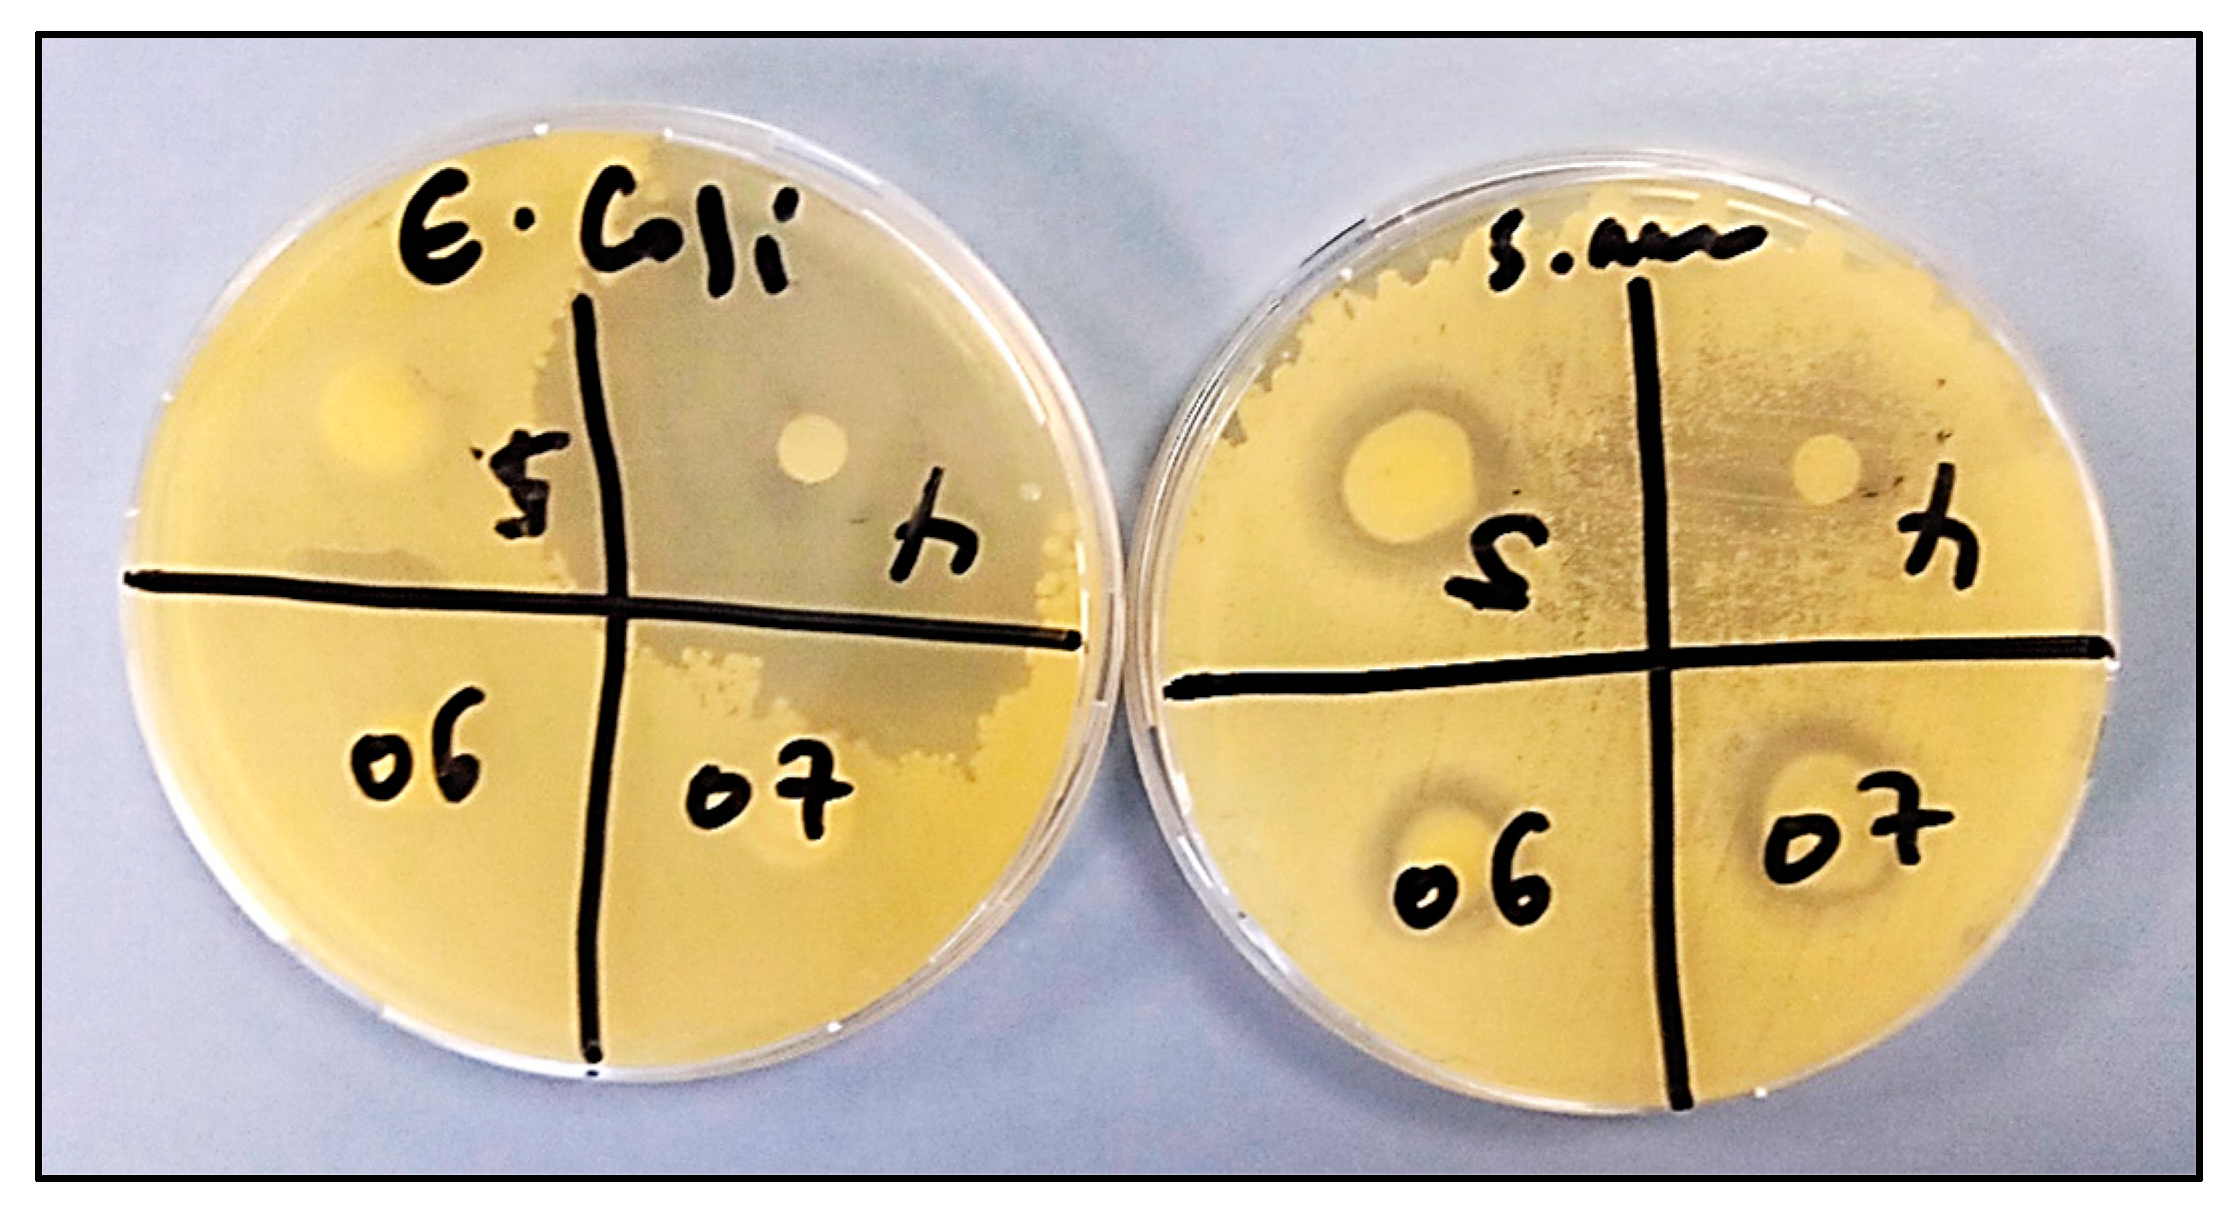
Sustainability 15 03189 g009

1. Introduction
People’s attention toward hair-care products is increasing more than in the past. As a result, hair-care products, especially shampoos intended for cleansing and beautification, are becoming a concern for many researchers. Shampoo is a preparation of surfactant intended to remove dirt, skin debris, and surface grease from the hair, shaft, and scalp without harmfully affecting the hair, scalp, or the health of the user when used under specified conditions [
1,
2]. The main function of shampoo is cleansing, owing to the presence of surfactants (surface-active agents). In addition, it also helps in lubrication, conditioning, moisturizing, styling, smoothing hair surfaces, and the fight against dandruff [
3]. Shampoo industries are shifting to herbal alternatives, as chemical-based shampoos have been reported to show side effects [
4]. Just like regular shampoo, herbal shampoo is a cosmetic formulation that uses herbs from plants for cleansing, conditioning, moisturizing, strengthening, and treating hair and scalp from dandruff [
5,
6]. The use of plant extracts in hair and skin care products can be appreciated by consumers as the latter highly seek to buy products that are ecologically friendly and safe to use.
In this regard, many researchers have investigated the use of botanical extracts in skin and hair care. For example, Ana et al. [
7] stated that incorporating bioactive extracts from different botanicals in cosmetic preparation helps to care for the body and plays a vital role in enhancing the biological functions of the skin by providing nutrients for the latter. Since plant products are rich in vitamins, antioxidants, essential and fixed oils, hydrocolloids, proteins, terpenoids, and other bioactive compounds, they have high health benefits when used in cosmetic preparations [
8,
9,
10,
11]. As herbal cosmetics are free from synthetic chemicals, they supply the body with nutrients, enhance health, and provide satisfaction to users. They are gaining popularity since people prefer natural over synthetic products [
12,
13]. These herbal plants grow in various ecological zones, and their composition varies depending on their geographical locations.
Ethiopia has a diversified class of plants that plays a vital role in healing, medication, and beautifying activity. Traditionally, different plant parts, especially roots, leaves, seeds, flowers, and fruits, have been used directly or indirectly in medicine and cosmetics. According to Tuasha et al. [
14], about 95% of the traditional medicine preparations in Ethiopia originate from plants. Plant species include
Eucalyptus globulus, Lepidium sativum L.,
Zingiber officinale Rosc.,
Carica papaya L.,
Allium sativum L.,
Ricinus communis, L.
adeonis, etc., abundantly grown in different regions of Ethiopia and have been used traditionally as medicine to heal various diseases. Traditionally, the seed of
L. sativum (garden cress) (
Figure 1), for instance, is crushed and mixed with lemon to treat abdominal pain and toothache [
15,
16]. According to Lev [
17], this seed is traditionally used in the treatment of stomachache, and for hair strengthening and an aphrodisiac. The plant seed contains abundant omega-6 fatty acid (44.37% 7,10-hexadecadienoic acid), omega-3 fatty acid of 7,10,13-hexadecatrienoic acid (9.93%), and other methyl esters such as steric acid (3.81%), hexadecanoic acid (4.31%), 15-tetracosenoic acid (5.68%), behenic acid (9.67%), and 11-octadecenoic acid (15.5%) [
18]. These enable the plant seed to have significant biological activities, such as broad-spectrum antimicrobial, antioxidant, and anti-inflammatory activities.
In addition,
Ricinus communis, which belongs to the family Euphorbiaceous, has shown great importance in pharmacology [
19]. Phytochemical studies have revealed that this species has a large variety of chemical components that exhibit pertinent pharmacological properties. According to Yeboah et al. [
20], the plant seeds dominantly possess triacylglyceride (TAG) molecules (diricino-leoylpalmitoyl-glycerol (0.9%), diricino-leoyllinoleoyl-glycerol (1.2%), diricino-leoyloleoyl-glycerol (5.6%), diricino-leoystearoyl-glycerol (8.2%), and triricinolein (84.1%)); phenolic compounds (such as flavonoids, phenolic acids, and tannins); and fatty acids (including ricinoleic acid (C18:1-OH), linoleic acid (C18:2), linolenic acid (C18:3), oleic acid (C18:1), palmitic acid (C16:1), and stearic acid (C18:0)). Owing to the presence of these important chemical compounds and other minor phytochemical constituents such as carotenoid, tocopherol, tocotrienol, and phytosterol in this plant, the latter are reported to possess antioxidant, anti-inflammatory, antidiabetic, central analgesic, antitumor, antinociceptive, and antiasthmatic activities [
21,
22,
23].
Another herbaceous plant,
Lippa adoensis Hochet. Ex. Koseret (Amharic: Koseret), belongs to the Verbenaceae family and is endemic to Ethiopia [
24]. Traditionally, the dried leaves of
L. adoensis were used in Ethiopian society as a constituent in the preparation of spiced butter, preservation of cow butter, and food flavoring. In Ethiopian traditional medicine, the leaves of
L. adoensis are used to treat several skin disorders such as eczema and superficial fungal infections [
25]. The work of Gemeda et al. [
26] revealed that the essential oil obtained from the leaves of the plant by hydrodistillation possessed a strong inhibitory effect on the growth of
Staphylococcus aureus and
Enterococcus hirae, and a moderate effect was observed for
Candida albicans and
Saccharomyces cerevisiae. Therefore,
L. adoensis essential oil extracts can be used in hair-care products such as shampoos, mainly as a preservative, and as a treatment for superficial fungal infections associated with hair and scalp.
Since human hair and scalp are widely exposed to different conditions such as sunlight, environmental pollution, and styling products, it needs regular washing and conditioning to keep hair and scalp feeling and looking clean. Therefore, appropriate shampooing is necessary to overcome such difficulties. However, shampoos most commonly available in markets are synthetic and contain many harsh chemicals associated with different health problems when used repeatedly and continuously [
27,
28,
29]. Therefore, this study aimed to formulate herbal shampoo using extracts of some medicinal plants growing in Ethiopia, and characterize the formulated products for their organoleptic and physicochemical parameters.
2. Materials and Methods
2.1. Sample Collection and Preparations
The leaves of Lippia adoensis Hochst ex. Walp koseret (hereafter abbreviated as LAK for essential oil extraction) were collected from G/Shasho Kebele, Tarcha Zuriya Woreda, Dawro Zone, South Nation Nationality People Regional State, Ethiopia. The collected leaves were properly packed using a high-density polyethylene bag with a zip lock. The mature dry seeds of R. communis (castor seed) and L. sativum (garden cress) were collected from Merkato market, Addis Ababa, Ethiopia, for seed oil extractions. The three plant materials were identified by a taxonomist at the Department of Biology and Biodiversity Management, College of Natural Sciences of Addis Ababa University, Ethiopia. Other oils, such as eucalyptus oil, coconut oil, and shea butter for shampoo formulations, were bought from Ethiopian Skin Beauty Secret, Addis Ababa, Ethiopia.
2.2. Chemicals, Reagents, and Apparatus
All chemicals used in the present work were of analytical grade, and all glassware was used after thorough washing and drying in an oven. The chemicals used included anhydrous sodium sulfate (Na2SO4) (99.0%, Research-Lab Fine Chem Industries, Mumbai, India), potassium hydroxide (KOH) (97.0%, Central Drug House (P) Ltd., New Delhi, India); sodium lauryl sulfate (SLS) (98.0%, Research-lab fine chem industries, India); ethylenediaminetetraacetic acid (EDTA) (99.0%, Samir Tech-Chem Pvt Ltd., Vadodara, India); carboxymethyl cellulose (CMC) (99.0%, Maa Kali Pharma Cum, Noida, India); gum acacia (98%, Sisco Research Laboratories Pvt Ltd., Mumbai, India); India ink (Loba Chemie Pvt Ltd., Mumbai, India); Mueller–Hinton agar (MHA) (HIMedia Laboratories Pvt Ltd., Mumbai, India); potato dextrose agar (PDA) (PG Micro Lab Solution LLP, India); petroleum ether (40–60 °C) (90%, Loba Chemie Pvt Ltd., Mumbai, India); and chromic acid (Chemicals UDYOG-121001, Faridabad, India). The following apparatus were also used: pH meter, thermometer, stalagmometer, hot plate, water bath, drying oven, Soxhlet extraction apparatus, commercial Clevenger type apparatus, heating mantle, analytical balance, grinder, mechanical stirrer, and mortar and pestle.
2.3. Experimental Procedures
2.3.1. Extraction of Essential Oil
First, freshly collected LAK leaves were thoroughly washed with tap water followed by distilled water, shed-dried, and crushed into powder using an electrical grinder. About 150 g of powder was taken into a 2 L clean, dry round bottom flask. Hydrodistillation was carried out after adding 1.5 L water and boiling chips for 3 h to complete the essential oil extraction using a commercial Clevenger-type apparatus. The extraction was conducted several times to collect enough oil for the characterization and formulation of the product. The oil sample obtained from each hydrodistillation was freed from moisture by adding enough anhydrous sodium sulfate. The resulting moisture-free essential oil sample was stored in the refrigerator at 4 °C for further analysis. The percent yield of the extracted essential oil from each sample based on various LAK leaf samples was determined using the following formula [
30,
31,
32]:
2.3.2. Extraction of Seed Oil
Mature, dry seeds of
L. sativum and
R. communis were ground into powder using an electric grinder. The seed oil extraction was conducted using an automatic Soxhlet extraction unit (Extraction Unit E-816 ECE, BUCHI Laboratories AG, Flawil, Switzerland). Twenty grams of the powdered seeds were placed into six cellulose thimbles and then transferred into each extraction chamber. About 150 mL of PET ether (40–60 °C) was added to each clean, dry extraction beaker containing boiling chips, and the extraction was conducted by setting the extraction time to 3 h, rinsing time to 5 min, and drying time to 20 min. At the end of the extraction, the solvent sent into the solvent tank using the instrument during the drying step was collected to a clean, dry flask and subsequently used for further extraction. Finally, the seed oils from each extraction beaker, containing a small amount of extraction solvent, were combined and further concentrated using a rotary evaporator. The amount of oil recovered and its percentage in the original sample were calculated as follows [
18,
33]:
2.4. GC–MS Analysis of LAK EO
The chemical composition analysis of LAK EO was conducted using gas chromatography (Thermo) hyphenated with a mass detector (GC–MS), at Shivaji University, Kolhapur, India. The GC apparatus equipped with a capillary column (length = 30 m, i.d. = 0.32 mm, and film thickness of 0.25 μm), coupled to a mass spectrometer (MS) type DSQII (Thermo) with a 70 eV detector impact of electrons was used. The carrier gas was helium at a rate of 1 mL min
−1; the injection volume was 1 μL; injector split mode 1:70. The injector temperature was 270 °C and the GC temperature program was held at 40 °C for 1 min, raised to 270 °C at a rate of 3 °C/min, and then held at 270 °C for 2 min. The mass spectra of each compound were scanned across the
m/
z range of 50 to 650. Identification of the compounds was obtained by comparing their mass spectra and retention times with those of standards (NIST14.lib) and those found in literature [
34].
2.5. Formulation of Herbal Shampoos
Four different herbal shampoo formulations were prepared according to the proportion given in
Table 1. The shampoos were formulated by applying the methods specified by Patel et al. [
5] and Sawarkar et al. [
35] with slight modifications. Beeswax, coconut oil, and shea butter were allowed to melt in a hot water bath at 75 °C. The oils were mixed with castor oil and
L. sativum in a 250 mL clean, dry round bottom flask and saponified with KOH solution using a reflux condenser by heating the flask at 75 °C for about 30 min. The weighed amounts of SLS were added to the mixture with continuous stirring using a mechanical stirrer. Thickeners and foam stabilizers (acacia gum, CMC, EDTA), stirred in the water phase for 30 min, were added to the above solution with continuous stirring. Finally, the LAK and eucalyptus essential oil were added to the shampoo solution after lowering the temperature to 35–40 °C, mixed thoroughly, allowed to cool to room temperature, and transferred to clean, dry shampoo bottles for further evaluation and characterization.
2.6. Evaluation of Herbal Shampoos
Different quality control tests, including organoleptic and physicochemical characteristics such as visual tests, pH, solid contents, and viscosity tests, were conducted for the formulated herbal shampoos to assess the quality of the product. In addition, specific tests for the formulations, including surface tension, foam volume, foam stability, dirt dispersion, surface morphology, skin sensitization tests, and preliminary stability study, were also carried out.
Physical Appearance/Visual Inspection: Physical appearance tests (organoleptic evaluation) on parameters, e.g., color, clarity, and odor, were carried out. These parameters were evaluated visually and via the smelling sensation, respectively.
pH Determination: The pH of shampoo (10% shampoo solutions) was determined in distilled water at room temperature using a calibrated pH meter [
27,
36]. Triplicate measurements were taken for each formulation to report mean ± standard deviation.
Dirt Dispersion Test: Two drops of shampoo were added to a large test tube containing 10 mL of distilled water. A dirt dispersion test was performed by adding a drop of India ink and then shaking the content. The amount of ink concentrated in the foam portion after shaking ten-times was then estimated as none, light, or heavy [
37,
38].
Surface Tension Measurement: It has been stated that a good shampoo should reduce the surface tension of pure water to about 40 dynes/cm [
39]. Surface tension lowering is one of the mechanisms concerned with detergency. The surface tension measurement of shampoo was conducted by the drop-count method using a stalagmometer. The latter was first rinsed thoroughly using a solution of chromic acid in distilled water and then with distilled water alone, as surface tension is highly affected by grease or other lubricants. The measurements were carried out with a 10% shampoo dilution in distilled water at room temperature. First, distilled water was sucked into the clean, dry stalagmometer until it reached the upper mark, and then the number of drops was recorded by counting until the liquid passed from the upper to the lower mark. Similar procedures were followed for 10% shampoo solutions, and the data for surface tension were calculated by applying Equation (3) [
39]. The measurements were repeated thrice and reported as mean ± standard deviation.
where W
1 is the weight of the empty beaker (g), W
2 is the weight of the beaker with distilled water (g), W
3 is the weight of the beaker with shampoo solution (g), n
1 is the number of drops of distilled water, n
2 is the number of drops of shampoo solution, R
1 is the surface tension of distilled water at room temperature = 72.8 dynes/cm, and R
2 is the surface tension of shampoo solution (dynes/cm).
Viscosity Measurement: About 100 mL of prepared shampoo solutions were taken in 250 mL of clean, dry beakers. The solution was then placed on a viscometer stand and allowed to stir with spindle #3. The viscosity of formulations was measured at varying revolutions per minute (rpm) to test the pseudo-plasticity of the preparation using an NDJ rotational viscometer. The viscosity of each formulation was recorded at varying speeds (i.e., 0.3, 0.6, 1.5, 3, 6, and 12 rpm) at room temperature (23.5 °C). The study kept the temperature and container size constant [
40].
Determination of Percentage Solid Contents: The exact weight of the shampoo was determined. The weight of a clean, dry evaporating dish with an evaporating 4 g shampoo dish was recorded. The evaporating dish with shampoo was then placed on the hot plate until complete evaporation of the liquid portion [
41,
42]. The weight of the remainder after drying was calculated, and the percent solid contents of shampoo were determined as per the following formula:
where M1 is the weight of the wet sample (before drying (g)) and M2 is the weight of the dry sample (after drying (g)).
Foaming and Foam Stability: The cylinder shake method was used to study shampoo formulation foaming capacities and foam stabilities [
43,
44,
45]. About 50 mL of 1% formulated shampoo solution were taken in a 250 mL capacity graduated cylinder, and the content was shaken vigorously ten times. The foam stability was measured by recording the foam volume produced by the shake test after 1, 3, and 5 min, respectively. The amount of foam each shampoo produced was recorded.
Skin Irritancy: A skin irritancy test was conducted by applying 1%
v/
v shampoo solution in distilled water over the skin. The applied shampoo solution remained in contact for about 2 h, and a response of any redness, itching, and inflammation was observed [
27].
Stability Studies: Stability studies were performed according to the International Conferences on Harmonization (ICH) guidelines for accelerated testing, with slight modifications. The shampoo samples were put in a humidity chamber at a temperature of 40 ± 2 °C and a relative humidity of 75% for two months [
2,
46]. The same samples were stored at room temperature (25 ± 2 °C) for two months. All samples were inspected for their organoleptic properties and physicochemical parameters such as pH, surface tension, viscosity, and foaming at the end of the storage period [
42,
47].
Analysis of Dirt Cleaning Effectivity of Herbal Shampoo by SEM: The surface morphology of hair samples before and after treatment with formulated and marketed shampoos was examined using a scanning electron microscope (SEM). Three hair samples: untreated hair (S-1), hair treated with herbal shampoo formula, F-4 (S-2), and hair treated with marketed shampoo (Head and Shoulders) (S-3), were prepared for SEM analysis as follows. The hair strands were dipped in a 250 mL graduated cylinder containing 20 mL of the shampoo solution, and continuously shacked for about 10 min. The solution was drawn off, and the hair strands were rinsed with 20 mL of distilled water for 1 min. The rinsing was repeated continuously, and the hair samples were dried by slightly pressing between pieces of filter paper [
46]. The dried hair samples were cut into small strands and mounted directly on the SEM sample stub by using double-side stitching carbon tape. The photomicrographs at appropriate magnification were obtained for surface characterization.
2.7. Antimicrobial Activities
Bacterial and Fungal Strains: The antibacterial and antifungal activities of three herbal shampoo formulations and one LAK essential oil were carried out using two pure bacterial cultures:
Staphylococcus aureus (ATCC–25923) and
Escherichia coli (ATCC–25922), and one clinical fungal isolate of
Aspergillus niger. Mueller–Hinton agar (MHA) medium and potato dextrose agar (PDA) were used to conduct the screening for antibacterial and antifungal activity, respectively [
25,
48].
Disc Diffusion Assay
Antibacterial Activity Studies: The antifungal and antibacterial assay was conducted using the disc diffusivity method. Fluconazole and gentamycin antibiotics were used as positive control for fungal and bacterial tests, respectively. The antibacterial activities against
E. coli and
S. aureus were studied using a diffusion disc over an MHA medium. Diffusion discs nearly 6 mm in diameter were prepared from Whatman No. 1 filter paper using a puncher, sterilized by spraying with 70% ethanol, autoclaved, and air-dried inside the hood [
49,
50]. The pure active bacterial culture of
E. coli and
S. aureus was inoculated into two separate Petri plates containing MHA media using a sterile loop. Each plate was then properly spread aseptically using a sterile spreader and divided into four quadrants. The previously prepared disc was aseptically placed into each quadrant using sterile forceps. About 10
L of test solutions and positive control were poured with a sterile micropipette into each disc. The plates were covered adequately with parafilm and kept in an incubator at 37 °C for 24 h. The zone of inhibition (ZOI) was measured after 24 h of incubation using a scale, and the experiment was repeated thrice.
Antifungal Activity Studies: The fungal pure culture of A. niger was obtained from the Food Process Engineering Department, Addis Ababa Science and Technology University. A colony of seven-day-old pure cultures was taken with a sterile loop and dissolved in 5 mL of distilled water. The pure cultures were then inoculated into sterile Petri plates over a PDA medium using a 3 mm sterile cork borer. Then, the plates were properly covered with parafilm and incubated for seven days at 28 °C. The fungal suspension was properly shaken with a vortex shaker and about 100 L suspensions were poured with a sterile micropipette into Petri plates containing PDA medium. It was spread over the medium using a sterile spreader. The 6 mm sterile discs were placed in Petri plates using sterile forceps, and 50 L test solutions and fluconazole control were charged into each disc. The plates were covered with parafilm and incubated at 28 °C. The experiment was repeated twice, and ZOI was measured using scales after 48 h incubation.
2.8. Statistical Analysis
Statistical analysis of data was conducted using IBM SPSS statistics 20. One-way analysis of variance (ANOVA) was used to determine significance, and p values < 0.05 were considered significant. Triplicate measurements were carried out for all tests, and data were stated as mean ± standard deviation.